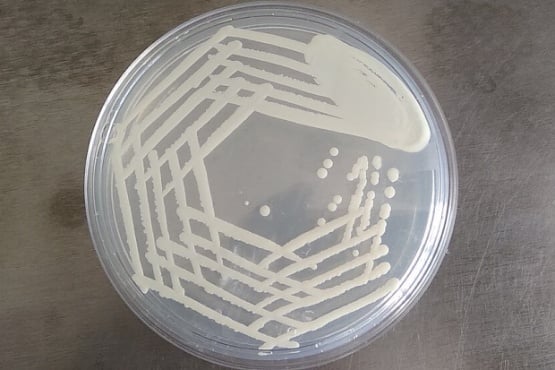
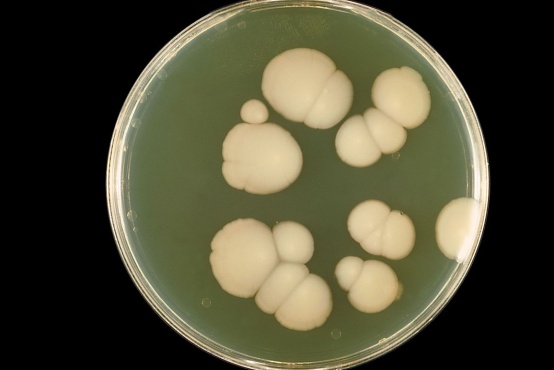
Candida albicans
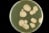
Candida albicans

- Какво представляват гъбичките?
- Кои са най-често срещаните гъбички?
- Какви изследвания се правят при съмнение за гъбички?
- Разноцветен лишей
- Гъбички на ръцете
- Гъбички на краката
- Гъбички на ноктите
- Гъбички в ушите
- Кандидоза
- Кандидоза на устната кухина - орофарингеална кандидоза
- Кандидоза на гениталиите
- Кандидоза на гънките
- Кандидоза по време на бременност
- Кандидоза при новородени
- Кандидоза на кожните придатъци
- Системна кандидоза
4. Разноцветен лишей
Разноцветният лишей е повърхностна гъбична инфекция и спада към кератомикозите.
4.1. Какво представлява разноцветният лишей?

Разноцветният лишей е гъбична инфекция, която засяга повърхностните слоеве - роговият слой на кожата.
Разноцветният лишей може да изглежда по различен начин. Обикновено обривът при разноцветен лишей е от петънца с фино залющване.
Цвета на петънцата може да бъде по-тъмен, по-светъл или сходен по цвят със здравата кожа. Вариацията в цвета на петънцата е голяма - могат да бъдат мръсно жълти, розови, червени, кафеникави и дори бели на цвят. От тук идва и името разноцветен лишей. Петънцата най-често стават бели в края на лятото, когато околната кожа пигментира.
Размера на петънцата също варира до няколко сантиметра в диаметър до доста по-големи по размер плаки, с неправилна форма в резултат от сливането на няколко петънца.
Разноцветният лишей засяга най-често гърба, гърдите, врата и шията и много по-рядко бедрата или горната част на ръцете.
Рядко разноцветният лишей може да бъде съпроводен от сърбеж.
Изображение: Sarahrosenau on Flickr.com, CC BY-SA 2.0, via Wikimedia Commons
4.2. Коя гъбичка причинява разноцветен лишей?

Разноцветният лишей се причинява от Malessezia furfur (Pityrosporum ovale). Този микроорганизъм е диморфна гъба и спада към групата на дрождите. Malessezia furfur е нормален сапрофит и расте в области, които са с повишена мастна секреция или с повишена влажност.
При състояния, при които има нарушение в имунитета съществува предпоставка за по-често засягане от разноцветен лишей.
Malessezia furfur отделя азелаинова киселина, която блокира синтеза на меланин (пигмент) и на това се дължи факта, че след излагане на слънце петънцата стават по-светли от околната кожа и обривът при разноцветен лишей става по-забележим.
По-тъмният цвят на петънцата при разноцветния лишей от своя страна се дължат на наличие на по-голямо количество микроорганизми в образуваните люспички.
При някои хора разрастването на Malessezia furfur (Pityrosporum ovale) води до образуване на малки пъпчици. Това състояние се нарича питироспорум фоликулит.
4.3. Кои фактори могат да доведат до разноцветен лишей?

Разноцветният лишей се причинява от бактерия, която нормално обитава всички хора и може да бъде открита дори при деца на 1 година. Естествено не всички хора боледуват.
Фактори за развитие на инфекцията могат да бъдат различни вътрешни и външни причини:
- лечение с кортикостероиди
- имуносупресивни състояния
- висока температура на околната среда
- висока влажност на околната среда
- използване на кремове или лосиони за тяло
- наднормено тегло
- повишено потене
- лоша хигиена
- неподходящо облекло
Разноцветния лишей се среща по-често при по-млади, отколкото при по-възрастни хора. Забелязва се по-лесно на по-тъмна кожа.
По-често от разноцветен лишей страдат хора, които живеят в по-топли страни или през по-топлите летни месеци.
4.4. Как се доказва разноцветнияt лишей?

Диагнозата на разноцветен лишей не е много трудна. Тя може да се постави дори и само при преглед.
За по-точно диагностициране и открояване на петънцата може да се направи изследване с лампа на Wood, нативен препарат или посявка в специална хранителна среда.
Нативният препарат е най-показателен за диагностициране на разноцветния лишей и има много интересен вид наподобяващ на „спагети с късчета месо”.
Прочетете повече за различните методи на изследване в рубриката:
4.5. Заразен ли е разноцветният лишей?

Malessezia furfur (Pityrosporum ovale) е част от нормалната флора на всеки един човек.
Разноцветният лишей може да бъда заразен само в изключително редки случаи, при които няма носителство на този микроорганизъм.
4.6. Какви могат да бъдат усложненията на разноцветния лишей?

За съжаление разноцветният лишей е често рецидивиращо състояние, защото се причинява от микроорганизъм, който е нормален обитател на кожата и е невъзможно да бъде премахнат напълно. За да не се появява отново, е необходимо този микроорганизъм да се подържа в по-ниска популация.
Разноцветния лишей много рядко може да бъде причина за сериозни усложнения. Такова сериозно усложнение е настъпване на сепсис при хора, които се хранят с помощта на тръбичка, която е разположена в областта на гърдите. Това усложнение е изключително рядко и е съпроводено едновременно и с промяна в имунитета.
4.7. Как се лекува разноцветния лишей?

Разноцветния лишей може да се лекува, както с лекарства през устата, така и с използване на различни локални средства. За лечение се използват противогъбични средства.
Лечението през устата се прилага по-рядко и обикновено при хора с нарушен имунитет, по-голямо засягане или ако не се повлияват от локалното лечение.
Локалните средства, които се използват за лечение на разноцветен лишей, най-често са под форма на шампоани, които съдържат кетоконазол, цинков пиритион, селенов сулфид. Биха могли да се използват и лосиони или кремове с противогъбичен състав.
4.8. Как се прави профилактика при разноцветен лишей?

Разноцветния лишей е често рецидивиращо състояние. Профилактиката на разноцветния лишей се състои в подържането на по-малък брой на микроорганизмите.
Профилактиката на разноцветен лишей се прави с помощта на измиване на няколко седмици с шампоани, които съдържат селенов сулфид или имидазолови съединения. Друг по-рядко използван метод е с приемане на лекарства през устата по определени схеми.

Коментари към Гъбички
-

www.framar.bg отговаря
-
Катя Михова
-

www.framar.bg отговаря
-
Л.Р.
-

www.framar.bg отговаря
-
Анка
-

www.framar.bg отговаря
-
Анета Георгиева
-

www.framar.bg отговаря
-
Гери
Зареждане на още 10 коментараКатя Михова
Здравейте!Имам гъбички във ухото,задушени ми е.Лекарят ми изписа 3 хапчета,които се пият през ден,кандизол,плюс почистване на 1 см навътре на ухото с риванол и мазане с тридерм,2 пъти на ден 10 дни.След това по 1 път на ден.Ще изчезнат ли по този начин на лечение Тези гъбички. Благодаря Ви.
Здравейте! Доверете се на преценката на лекаря и следвайте указанията за лечение. Предписаната терапия е противогъбична.
Здравейте!Имам гъбички във ухото,задушени ми е.Лекарят ми изписа 3 хапчета,които се пият през ден,кандизол,плюс почистване на 1 см навътре на ухото с риванол и мазане с тридерм,2 пъти на ден 10 дни.След това по 1 път на ден.Ще изчезнат ли по този начин на лечение Тези гъбички. Благодаря Ви.
Л.Р.
Здравейте! Има ли значение дължината на нокътя на краката за вземане на материал за изследване за микоза, тъй като си подрязвам ноктите доста в дълбочина. Трябва ли за изчакам малко да израснат, за да си насроча такова изследване? Благодаря!
Здравейте! Бихте могли да изчакате нокътя да израсте няколко милиметра, за да може да се изреже малък участък за изследването.
Здравейте! Има ли значение дължината на нокътя на краката за вземане на материал за изследване за микоза, тъй като си подрязвам ноктите доста в дълбочина. Трябва ли за изчакам малко да израснат, за да си насроча такова изследване? Благодаря!
Анка
можели да комбинираме 5 масла в едно и даси направим лечение
Лечението на гъбична инфекция се назначава от лекар въз основа на вида, тежестта и локализацията на инфекцията и се провежда с антимикотични лекарства.
можели да комбинираме 5 масла в едно и даси направим лечение
Анета Георгиева
Здравейте, възможно ли е микробиологията да даде фалшиво отрицателен резултат? Тъй като имам доста бяло течение. Бях си пуснала в рамките на 2 месеца в три лаборатории микробиологично изследване на вагинален секрет и трите резултата са отрицателни за бактерии и гъбички.
Здравейте! При еднократно изследване, неправилно взимане на проба и култивиране на микроорганизми може да се получи фалшиво отрицателен резултат. При вас са извършени 3 микробиологични изследвания и те не се открили болестотворни микроорганизми, поради което вероятността за фалшиво отрицателен резултат е изключително малка.
Здравейте, възможно ли е микробиологията да даде фалшиво отрицателен резултат? Тъй като имам доста бяло течение. Бях си пуснала в рамките на 2 месеца в три лаборатории микробиологично изследване на вагинален секрет и трите резултата са отрицателни за бактерии и гъбички.
Гери
Здравейте, искам да попитам дали гъбичните инфекции могат да доведат до спонтанен аборт
Здравейте! Съществува възможна връзка между наличието на вагинална кандидоза и преждевременното раждане.
Здравейте, искам да попитам дали гъбичните инфекции могат да доведат до спонтанен аборт